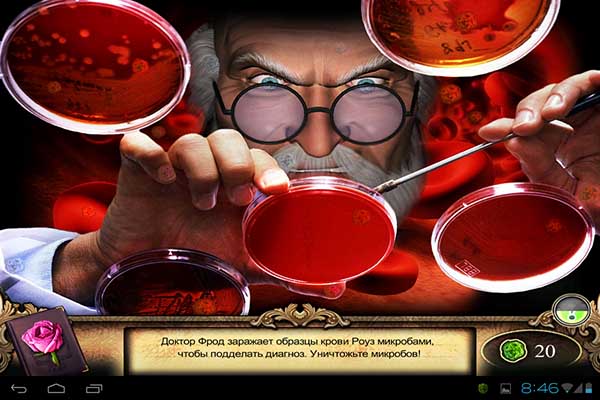
Redrum. Мертвый дневник (2013)

Redrum. Мертвый дневник (2013)

Роза видит несправедливо убитых людей, чьи предсмертные желания не были выполнены. Ее рационально мыслящий отец отказывается верить ее призрачным видениям и помещает девочку в сумасшедший дом, где она попадает прямиком в лапы зловещего доктора. Помогите Розе, используя экстрасенсорные способности, раскрыть чудовищные убийства и перехитрить маньяка - убийцу.

Особенности:
- 42 захватывающие локации
- Раскройте чудовищные убийства в семи главах
- Впечатляющая графика и неземная музыка
Системные требования: Android 2.3 и выше
Язык интерфейса: русский
Путь для кэша: \sd\android\obb\
Скачать игру "Redrum. Мертвый дневник" (120,2 МБ):
marina199 13/08/13 Просмотров: 1939
0
